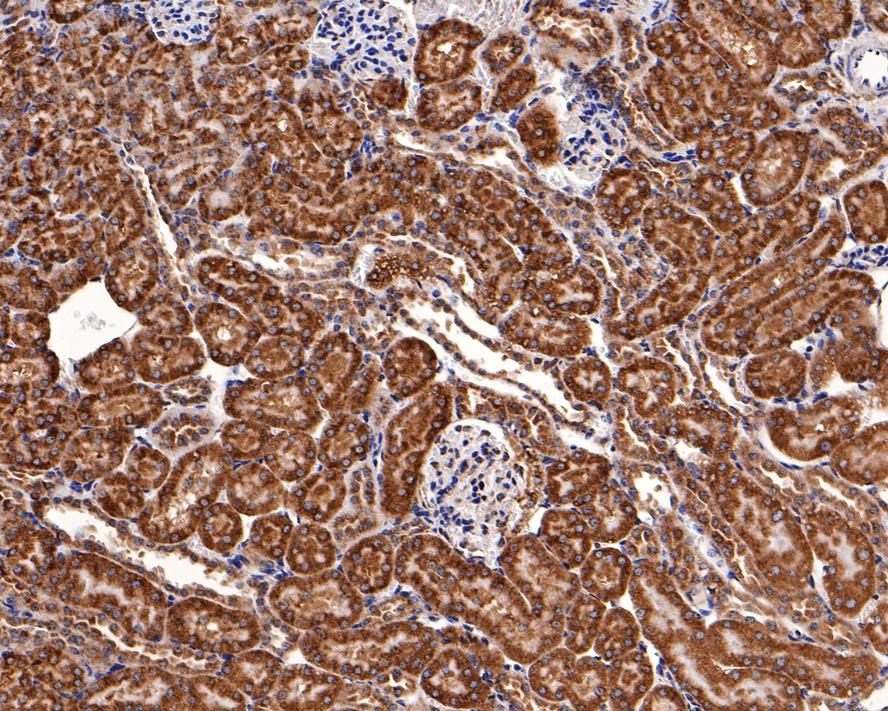
verifiedActivity

购物车
 您的购物车当前为空
您的购物车当前为空
Anti-BCL2A1 Antibody (2U316) 是一种 Rabbit 抗体,靶向 BCL2A1。Anti-BCL2A1 Antibody (2U316) 可用于 ICC/IF,IF,IHC-Fr,IHC-P,WB。
别名 HBPA1, GRS, BFL1, BCL2L5, BCL2 related protein A1, ACC-2, ACC2, ACC-1, ACC1
Anti-BCL2A1 Antibody (2U316) 是一种 Rabbit 抗体,靶向 BCL2A1。Anti-BCL2A1 Antibody (2U316) 可用于 ICC/IF,IF,IHC-Fr,IHC-P,WB。
| 规格 | 价格 | 库存 | 数量 |
|---|---|---|---|
| 25 μL | ¥ 795 | 5日内发货 | |
| 50 μL | ¥ 1,385 | 5日内发货 | |
| 100 μL | ¥ 2,495 | 5日内发货 |
TargetMol的所有产品仅用作科学研究或药证申报,不能被用于人体,我们不向个人提供产品和服务。请您遵守承诺用途,不得违反法律法规规定用于任何其他用途。
| 产品描述 | Anti-BCL2A1 Antibody (2U316) is a Rabbit antibody targeting BCL2A1. Anti-BCL2A1 Antibody (2U316) can be used in ICC/IF,IF,IHC-Fr,IHC-P,WB. |
| 别名 | HBPA1, GRS, BFL1, BCL2L5, BCL2 related protein A1, ACC-2, ACC2, ACC-1, ACC1 |
| Ig Type | IgG |
| 克隆号 | 2U316 |
| 反应种属 | Human,Mouse (predicted:Rat) |
| 验证活性 | 1. Immunohistochemical analysis of paraffin-embedded human tonsil tissue with Rabbit anti-BCL2A1 antibody (TMAB-00200) at 1/50 dilution. The section was pre-treated using heat mediated antigen retrieval with Tris-EDTA buffer (pH9.0) for 20 min. The tissues were blocked in 1% BSA for 20 min at room temperature, washed with ddH2O and PBS, and then probed with the primary antibody (TMAB-00200) at 1/50 dilution for 1 hour at room temperature. The detection was performed using an HRP conjugated compact polymer system. DAB was used as the chromogen. Tissues were counterstained with hematoxylin and mounted with DPX. 2. Immunohistochemical analysis of paraffin-embedded mouse kidney tissue with Rabbit anti-BCL2A1 antibody (TMAB-00200) at 1/400 dilution. The section was pre-treated using heat mediated antigen retrieval with Tris-EDTA buffer (pH9.0) for 20 min. The tissues were blocked in 1% BSA for 20 min at room temperature, washed with ddH2O and PBS, and then probed with the primary antibody (TMAB-002000) at 1/400 dilution for 1 hour at room temperature. The detection was performed using an HRP conjugated compact polymer system. DAB was used as the chromogen. Tissues were counterstained with hematoxylin and mounted with DPX. 3. Immunohistochemical analysis of paraffin-embedded human kidney tissue with Rabbit anti-BCL2A1 antibody (TMAB-00200) at 1/400 dilution. The section was pre-treated using heat mediated antigen retrieval with Tris-EDTA buffer (pH9.0) for 20 min. The tissues were blocked in 1% BSA for 20 min at room temperature, washed with ddH2O and PBS, and then probed with the primary antibody (TMAB-00200) at 1/400 dilution for 1 hour at room temperature. The detection was performed using an HRP conjugated compact polymer system. DAB was used as the chromogen. Tissues were counterstained with hematoxylin and mounted with DPX 4. Immunohistochemical analysis of paraffin-embedded mouse liver tissue with Rabbit anti-BCL2A1 antibody (TMAB-00200) at 1/100 dilution. The section was pre-treated using heat mediated antigen retrieval with Tris-EDTA buffer (pH9.0) for 20 min. The tissues were blocked in 1% BSA for 20 min at room temperature, washed with ddH2O and PBS, and then probed with the primary antibody (TMAB-00200) at 1/100 dilution for 1 hour at room temperature. The detection was performed using an HRP conjugated compact polymer system. DAB was used as the chromogen. Tissues were counterstained with hematoxylin and mounted with DPX. |
| 应用 | ICC/IFIFIHC-FrIHC-PWB |
| 推荐剂量 | WB: 1:500-2000; IHC-P: 1:50-200; IHC-Fr: 1:50-200; ICC/IF: 1:50-200; IF: 1:50-200 |
| 抗体种类 | Monoclonal |
| 宿主来源 | Rabbit |
| 亚细胞定位 | Cytoplasm. |
| 组织特异性 | Seems to be restricted to the hematopoietic compartment. Expressed in peripheral blood, spleen, and bone marrow, at moderate levels in lung, small intestine and testis, at a minimal levels in other tissues. Also found in vascular smooth muscle cells and h |
| 构建方式 | Recombinant Antibody |
| 纯化方式 | Protein A purified |
| 性状 | Liquid |
| 缓冲液 | 0.01M TBS (pH7.4) with 1% BSA, 0.02% Proclin300 and 50% Glycerol. |
| 浓度 | 1 mg/mL |
| 研究背景 | This gene encodes a member of the BCL-2 protein family. The proteins of this family form hetero- or homodimers and act as anti- and pro-apoptotic regulators that are involved in a wide variety of cellular activities such as embryonic development, homeostasis and tumorigenesis. The protein encoded by this gene is able to reduce the release of pro-apoptotic cytochrome c from mitochondria and block caspase activation. This gene is a direct transcription target of NF-kappa B in response to inflammatory mediators, and is up-regulated by different extracellular signals, such as granulocyte-macrophage colony-stimulating factor (GM-CSF), CD40, phorbol ester and inflammatory cytokine TNF and IL-1, which suggests a cytoprotective function that is essential for lymphocyte activation as well as cell survival. Alternatively spliced transcript variants encoding different isoforms have been found for this gene. [provided by RefSeq, Jul 2008] |
| 免疫原 | A synthesized peptide: human Bcl 2 A1 |
| 抗原种属 | Human |
| 基因名称 | BCL2A1 |
| 基因ID | |
| 蛋白名称 | Bcl-2-related protein A1 |
| 研究领域 | Bcl2 Family |
| 功能 | Retards apoptosis induced by IL-3 deprivation. May function in the response of hemopoietic cells to external signals and in maintaining endothelial survival during infection. |
| 分子量 | Theoretical: 29 kDa. |
| 储存方式 | Store at -20°C or -80°C for 12 months. Avoid repeated freeze-thaw cycles. |
| 运输方式 | Shipping with blue ice. |